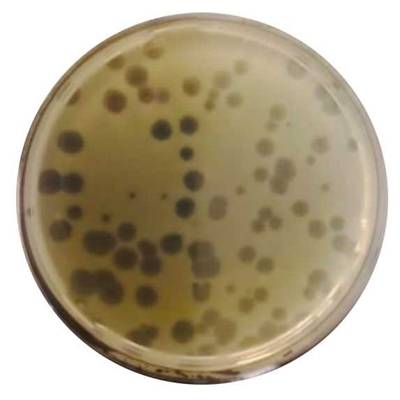
Borderline number of plaques which can be counted and evaluated.

EnviroMail 155 Australia
Tracking the unseen: the identification of somatic coliphages in all water types
Given the ever-increasing demands on drinking water quality and social pressure for the reuse of treated wastewater, somatic coliphages are being monitored as indicators for evaluating the efficiency of water treatment and purification processes. Therefore, it is important to monitor their presence in specific types of water, particularly water intended for human consumption.
Introduction
Faecal Indicator Bacteria such as Escherichia coli have been long established as indicators of faecal contamination. However, they are not suitable as indicators of viruses due, in part, to their larger size which impacts settling and transport. Viruses can persist longer in the environment, be transported further, and show higher resistance to treatment compared to bacterial indicators. Pathogenic enteric viruses can cause highly unpleasant infectious diseases of the digestive tract in humans.
Somatic coliphages are viruses that infect bacteria such as Escherichia coli. They are ideal indicators of viral faecal contamination in water since they are non-pathogenic to humans, they thrive in the same conditions and exhibit very similar behavior to viruses that are hazardous to humans.

Figure 1: Example of plaques on the Petri dish

Figure 2: The Phi X 174 bacteriophage illustrative picture
credit: Fdardel
Why is coliphages testing essential?
Coliphages play a crucial role as indicators of water quality. Their presence can signal potential risks to public health, such as the presence of enteric viruses.
Monitoring somatic coliphages serves as an effective warning system against faecal contamination in water supplies. When higher levels of these viruses are detected, it prompts further investigations and interventions, thereby aiding in the prevention of waterborne diseases. Moreover, tracking somatic coliphage levels is essential for assessing the effectiveness of water treatment processes, including disinfection and filtration, thus safeguarding water quality.
Ensuring compliance with regulatory requirements and standards for the sanitary quality of drinking water is another critical aspect protecting the public health. Early and continuous monitoring provides an insight into the potential presence of pathogenic viruses. This makes it a valuable tool for the prevention of diseases and managing risks. Understanding the patterns and behavior of coliphages in different environmental conditions enhances our ability to predict and mitigate potential outbreaks.
Legislation
The National Water Quality Management Strategy published the Australian Drinking Water Guidelines 6 2011 Version 3.8 Updated in September 2022, states that Coliphages should not be detected in any 100mL sample. If used as an indicator and detected in drinking water, immediate action should be taken including investigation of potential sources of faecal contamination.
The methodology for somatic coliphages determination
Since somatic coliphages are viruses, the analysis requires a bacterial host for the coliphage to grow inside. This host requirement means that water analysis is carried out differently compared to determination of bacterial parameters.
| Method | Suitable samples |
| In-house pour plates | Estuarine waters; Fresh waters; Industrial waters – Treated, recirculating. Marine waters; Potable Waters; Sewage |
Evaluation of cultivation: quantitation of plaques (unit PFU—plaque forming unit)
A: An optimal number of plaques for counting and evaluation.

B: Borderline number of plaques which can be counted and evaluated. Further dilution of sample is needed.
C: Sample is too contaminated for plaques to be enumerated and evaluated. Overgrown plates are discarded and sample dilution must be applied.

Best sampling and transportation practice
For the proper execution of the analysis and to deliver high-quality and reliable results to clients, it is essential to ensure:
-
Validated matrices: drinking, raw, bottled, surface, ground, processing and wastewater.
-
Use the correct sample container: for coliphages analysis the 250mL plastic bottle containing sodium thiosulphate (this solution neutralises chlorine from water pipes, preventing the death of live microorganisms and phages that are sensitive to the presence of chlorine, and thereby avoiding the reporting of false negative results).
-
Minimum amount of sample: 100 mL of tested water.
-
Compliance with suitable conditions during sample transport to the lab must be ensured: cooling of sample from 2 to 8°C.
-
The analysis must be performed within three days (holding time 72 hours) of sampling.
References
USEPA Chapter 16 June 2001, USEPA Manual of Methods for Virology Chapter 16 Procedures For Detecting Coliphages.
ISO 10705-2 Water quality – Detection and enumeration of bacteriophages – part 2: enumeration of somatic coliphages.
NHMRC, NRMMC (2011) Australian Drinking Water Guidelines Paper 6 National Water Quality Management Strategy. National Health and Medical Research Council, National Resource Management Ministerial Council, Commonwealth of Australia, Canberra.
Get in touch with us
We would love to hear about how our services for this emerging class of PFAS might assist with your project needs, and we welcome feedback on how we might improve or expand our services to meet your needs. Don’t hesitate to get in contact with your nearest ALS laboratory to discuss your PFAS testing requirements.
Brisbane
Sydney
Melbourne
Perth
Scoresby
New Zealand
Download as a PDF























